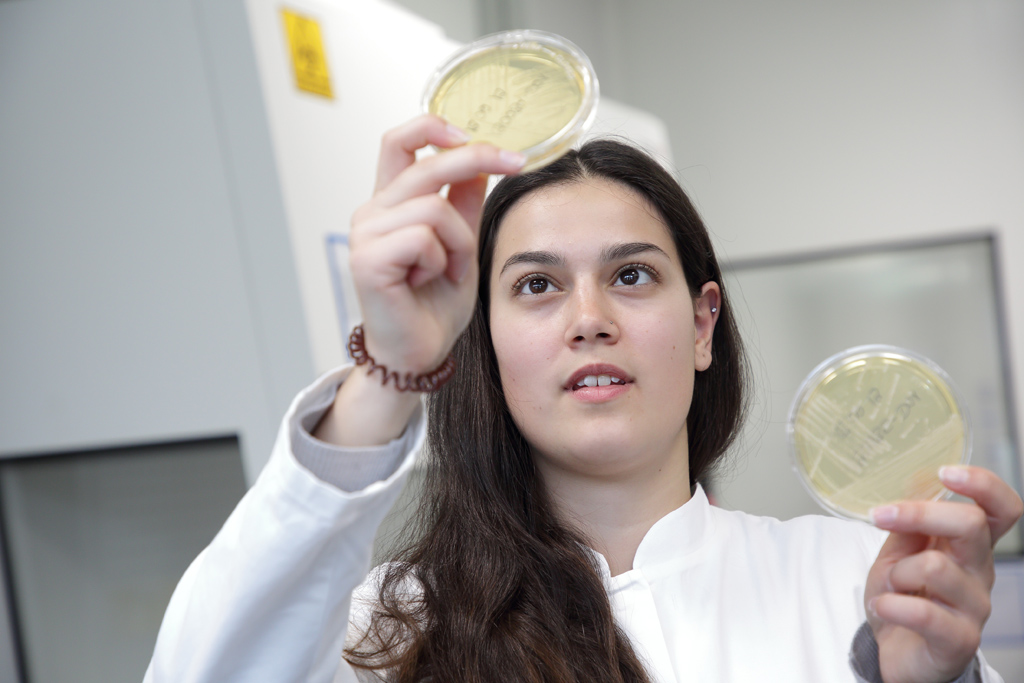

spazio_left_interna
Read more
Unser Standort im Industriepark Singen umfasst alle Funktionen der Herstellung und Verpackung von sterilen Arzneimitteln sowie die dafür notwendige Logistik für Rohstoffe, Halbfabrikate und Fertigware.
Unser Standort im Industriepark Singen umfasst alle Funktionen der Herstellung und Verpackung von sterilen Arzneimitteln sowie die dafür notwendige Logistik für Rohstoffe, Halbfabrikate und Fertigware.
Titolo
Corpo

Die Organisationsstruktur der BIPSO GmbH ist gekennzeichnet von flachen Hierarchien und gliedert sich in verschiedene Abteilungen. Diese sind direkt oder indirekt an der Herstellung der Kontrastmittel beteiligt. Gerade die enge Zusammenarbeit zwischen den Abteilungen bietet BIPSO den Vorteil, schnell und effektiv die betrieblichen Abläufe zu lenken, Entscheidungen zu treffen und gemeinsam Ziele zu erreichen.
Die Herstellung der Kontrastmittel beginnt beim Einkauf der Rohstoffe und Materialien.
Primär- bzw. Sekundärpackmittel werden von der Abteilung Purchasing beschafft.
Um die termingerechte Produktionsplanung sowie den gesamten Lagerprozess kümmert sich die Abteilung Supply Chain.
Das Herzstück der BIPSO GmbH ist die Produktion. Diese untergliedert sich in die Organisationseinheiten Sterile Production und Sterile Packaging. Wobei in der Sterilen Produktion die Herstellung und Abfüllung der Kontrastmittel stattfindet, während das Produkt in der sterilen Verpackung optisch kontrolliert und versandfertig verpackt wird. In diesen beiden Bereichen sind rund 2/3 unserer Mitarbeiter beschäftigt.
Zur Produktionsabteilung gehört auch die Abteilung Manufacturing, Science & Technology. Diese Abteilung ist für die Validierung von Änderungen oder Inbetriebnahmen von Produktionslinien verantwortlich. Im GMP-Umfeld ist es wichtig, dass alle Prozesse validiert (überprüft) werden. Außerdem kümmern sie sich um alle produktionsrelevanten Dokumente.
Die Mitarbeiter der Technischen Abteilung (Technical Department) kümmern sich um die Wartung und Instandhaltung unserer Betriebs- und Haustechnik und sorgen somit für einen störungsfreien Produktionsablauf.
Klicken für mehr Bilder image #2image #3image #2image #3
Klicken für mehr Bilder image #2image #3image #2image #3
Qualität ist im sterilen Bereich unerlässlich. Zu den Aufgaben der Quality Abteilung gehören:
Die Kontrolle der Einhaltung der GMP Richtlinien, die Schulung von Mitarbeitern und die Entscheidung über Freigaben der Endprodukte.
Außerdem unterstützt die Abteilung Performance Management den Standort, indem sie sich mit der der kontinuierlichen Optimierung der Prozesse und Arbeitsabläufe beschäftigt.
Selbstverständlich wird Gesundheit, Sicherheit und Umwelt groß geschrieben bei BIPSO. Darum kümmert sich die Abteilung HSE (Health, Safety & Environment). Diese Abteilung beschäftigt sich mit der Planung, Umsetzung, Kontrolle und Optimierung von betrieblichen Prozessen in den Bereichen Gesundheitsschutz, Arbeitssicherheit und Umweltmanagement.
Neben diesen Abteilungen unterstützen die kaufmännischen Bereiche die BIPSO GmbH in unternehmerischen Entscheidungen und allen administrativen Prozessen.
Hier sehen Sie die Organisationsstruktur
Read more
Unser Standort im Industriepark Singen umfasst alle Funktionen der Herstellung und Verpackung von sterilen Arzneimitteln sowie die dafür notwendige Logistik für Rohstoffe, Halbfabrikate und Fertigware.
Unser Standort im Industriepark Singen umfasst alle Funktionen der Herstellung und Verpackung von sterilen Arzneimitteln sowie die dafür notwendige Logistik für Rohstoffe, Halbfabrikate und Fertigware.



